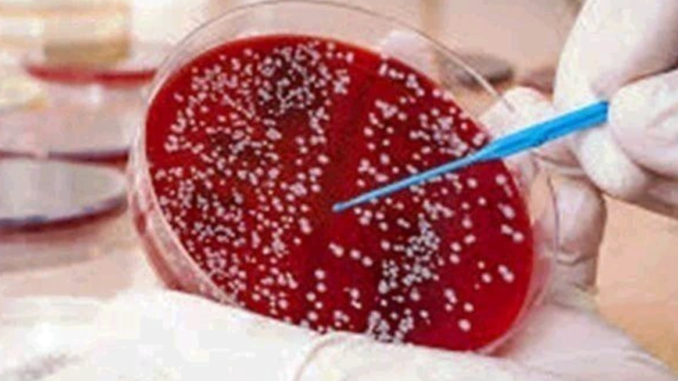

Blood cancer is one of the deadliest diseases today. It attacks your blood cells and weakens your immune system. While genetics play a role, lifestyle choices can increase your risk. Certain foods and habits can silently damage your body and make blood cancer more likely.
Here are 5 things you must avoid in excess if you want to protect your health:
1. Sugary Drinks
Too much sugar can weaken your immune system and increase inflammation. Soft drinks, energy drinks, and sweetened juices are the worst offenders. Replace them with water, green tea, or natural fruit juices.
2. Processed Meat
Sausages, bacon, and other processed meats contain chemicals that may harm blood cells. Eating them often can increase your risk of blood-related diseases. Opt for lean meats or plant-based proteins instead.
3. Alcohol
Excessive drinking harms your liver and blood cells. Even moderate alcohol over time can increase cancer risks. Limit alcohol intake or avoid it completely to protect your body.For more, Read Full; Original.